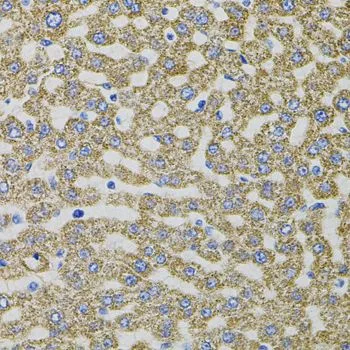

IHC-P analysis of rat liver tissue using GTX33183 EPO antibody.
EPO antibody
GTX33183
ApplicationsWestern Blot, ImmunoHistoChemistry, ImmunoHistoChemistry Paraffin
Product group Antibodies
ReactivityHuman, Mouse, Rat
TargetEPO
Overview
- SupplierGeneTex
- Product NameEPO antibody
- Delivery Days Customer9
- Application Supplier NoteWB: 1:500 - 1:2000. IHC-P: 1:100 - 1:200. *Optimal dilutions/concentrations should be determined by the researcher.Not tested in other applications.
- ApplicationsWestern Blot, ImmunoHistoChemistry, ImmunoHistoChemistry Paraffin
- CertificationResearch Use Only
- ClonalityPolyclonal
- ConjugateUnconjugated
- Gene ID2056
- Target nameEPO
- Target descriptionerythropoietin
- Target synonymsDBAL, ECYT5, EP, MVCD2, erythropoietin, epoetin
- HostRabbit
- IsotypeIgG
- Protein IDP01588
- Protein NameErythropoietin
- Scientific DescriptionThis gene encodes a secreted, glycosylated cytokine composed of four alpha helical bundles. The encoded protein is mainly synthesized in the kidney, secreted into the blood plasma, and binds to the erythropoietin receptor to promote red blood cell production, or erythropoiesis, in the bone marrow. Expression of this gene is upregulated under hypoxic conditions, in turn leading to increased erythropoiesis and enhanced oxygen-carrying capacity of the blood. Expression of this gene has also been observed in brain and in the eye, and elevated expression levels have been observed in diabetic retinopathy and ocular hypertension. Recombinant forms of the encoded protein exhibit neuroprotective activity against a variety of potential brain injuries, as well as antiapoptotic functions in several tissue types, and have been used in the treatment of anemia and to enhance the efficacy of cancer therapies. [provided by RefSeq, Aug 2017]
- ReactivityHuman, Mouse, Rat
- Storage Instruction-20°C or -80°C,2°C to 8°C
- UNSPSC12352203
References
- Leigh J, Juriasingani S, Akbari M, et al. Endogenous H(2)S production deficiencies lead to impaired renal erythropoietin production. Can Urol Assoc J. 2019,13(7):E210-E219. doi: 10.5489/cuaj.5658Read this paper







![The cell proliferation of the TF-1 human erythroleukemic cell line induced by Human Erythropoietin/EPO and neutralization by Erythropoietin Antibody. Proliferation elicited by Recombinant Human Erythropoietin/EPO (0.4 ng/mL) is neutralized by increasing concentrations of EPO antibody [HL2752] (GTX639615).](https://www.genetex.com/upload/website/prouct_img/normal/GTX639615/GTX639615_T-45278_20240524_Functionalassay_24052802_265.webp)